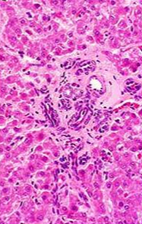
<p>What is being shown here?</p>

Liver and biliary system pathology 2
1/50
There's no tags or description
Looks like no tags are added yet.
Name | Mastery | Learn | Test | Matching | Spaced | Call with Kai |
|---|
No analytics yet
Send a link to your students to track their progress
51 Terms
What type of necrosis is usually seen in the liver?
Coagulative —> intact but dead hepatocytes → cells shrunken, intensely eosinophilic w/ altered nuceli
What are the different types of coagulative necrosis?
Multifocal
Zonal
Massive / diffuse
Describe multifocal necrosis
Aggregates of necrotic hepatocytes —> random i.e. no pattern within lobules
With disseminated infections
What are the different types of zonal necrosis?
In particular part of lobule / acinus
Centrolobular / periacinar necrosis
Mid-zonal necrosis (rare)
Periportal/ biliary necrosis

What is being shown here?

Multifocal coagulative necrosis - two foci that have lost cellular outline + nuclar debris
Caused by Tyzzer’s dx —> Clostidium piliforme
What is being shown here?

Haemorrhagic dx in rabbit caused by calicivirus —> focal coagulative necrosis:
Hypereosinophilic cytoplasm, shrunken nuclei
What is being shown here?

Disseminated multiocal necrosis
Small pale tan spots are the necrotic foci (surrounded by red rings = haemorrage / necrosis)
Why is centrobular / periacinar necrosis most frequent?
Hepatocytes most at tisk of hypoxia
Metabolically active (cytochrome P450)

When would peri-portal necrosis occur?
Unusual e.g. phosphorus poisoning
Biliary inflammation
Portal circulation
When would massive (diffuse) necrosis occur?
Necrosis of entire lobe(s)
With extensive zonal necrosis
Circulatory disorder (infarction)
Pigs with vitamin E / selenium deficiency (Hepatosis dietetica)
Torsion of the lobes

Describe hepatosis dietetica in pigs
Associated oedema of gall bladder wall & Mulberry Heart Dx (multifocal myocardial haemorrhage & myofibre degen)

What are the different options for resolution after necrosis?
regeneration of hepatocytes
replacement of parenchyma by fibrous scar (due to destruction of reticular framework)
(if not resolution, removal of dead hepatocytes)
What are the different areas that fibrosis can occur?
At the site of necrosis, pattern depends on distribution of injury
periportal / biliary fibrosis
centrolobular / periacinar fibrosis
diffuse / bridging fibrosis (areas of fibrosis might join up after massive necrosis)

What is being shown here?

Extensive fibrosis between hepatic cords (dissecting fibrosis)
collagen extends out along sinusoids, growth between hepatocytes → interferes with blood flow i.e. passage of nutrients, metabolites etc.
Often leads to further degeneration and necrosis of hepatocytes
What is hepatic cirrhosis?
End stage liver dx (irreversible) due to several causes
what are the characteristic features of hepatic cirrhosis?
DEGENERATION —> disruption of entire liver architecture
REGENERATION —> regenerative nodules of hepatocytes (loss of lobular structure so unable to carry out function)
REPAIR —> bridging fibrosis [central pathogenic process]
What are the features of the regenerative nodules in liver cirrhosis?
composed of hepatocytes
lack of lobular organisation [no cords, no central vein, no triad]
often hydropic degeneration of hepatocytes
surrounded by fibrous connective tissue
What further attempts of regeneration can be made with Hepatic cirrhosis?
Bile duct proliferation
What is being shown here?

regenerative nodule, which is surrounded by fibrosis and contains hepatocytes which lack sinusoidal organisation (no sinusoids in between hepatocytes)
What are further characteristics of hepatic cirrhosis?
parenchymal injury and fibrosis are diffuse (i.e. throughout the whole organ)
balance between regeneration and constrictive scarring ® nodularity
reorganisation of vascular structure [intrahepatic anastomoses]
central pathogenic process —> progressive fibrosis
What is being shown here?

Large number of small nodular lesions, which are the regenerative nodules
Tissue between these is pale tan and depressed from the surface in comparison
End stage —> cannot improve
What is being shown here?

Liver cirrhosis
Multiple regenerative nodules of varying size, surrounded by fibrosis —> stained blue
Very little functional parenchyma left
What is being shown here?

Extensive fibrosis in hepatic cirrhosis
Regenerative nodules larger in size
What is being shown here?

Cut surface of a cirrhotic liver
Pale tan to yellow bridging areas are collagen or fibrosis, & the dark tan areas = remaining hepatic parenchyma.
bridging fibrosis seen
What is thought to cause Hepatic cirrhosis in dogs & other species?
Majority of cases idiopathic
Dogs = persistent CAV-1 or leptospira infection
What are the rare things that could cause cirrhosis?
Parasitic (ascaris spp. & liver flukes)
Cardiac (chronic passive congesion due to CHF)
Post-necrotic (toxins, infectious agents)
Pigment (with haemochromatosis)
Biliary (due to chronic cholangitis in cats)
Toxic
What can occur secondary to hepatic cirrhosis?
Jaundice (icterus) due to impaired hepatic function
always diffuse because in systemic circulation
Ascites due to portal hypertension
Hepatoencephalic syndrome —> failure of liver to remove ammonia from blood → CNS signs
What is being shown here?

Severe jaundice due to leptospirosis
What is being shown here and what is it due to?

Jaundice
High bilirubin levels in the blood → yellow tinge of ALL tissues
seen only grossly
What are the different types of jaundice you can get?
Pre-hepatic = excessive haemolysis
Hepatic = severe hepatic injury
Post-hepatic = obstructed bile flow
What are the components of bile?
Bile = yellow-green in colour
water
cholesterol
bile salts (Na + K)
bile pigments (bilirubin) from Hb molecule
globin + haem (haem = broken down into iron & biliverdin → bilirubin)
What are the features of pre-hepatic jaundice?
Due to excessive haemolysis of erythrocytes in peripheral blood
Infections —> lepto, EIA, haemolytic streptococci, anthrax, snake venom
massive internal haemorrhage
incterus neonatorum (bilirubin glucoronyl transferase still insufficient)
Unconjugated bilirubin in blood
What are the features of hepatic jaundice?
Due to severe hepatic injury by toxic substances or infectious agents (e.g. lepto)
Damaged hepatocytes do not uptake bilirubin or perform conjugation (unconjugated bilirubin)
Severe hepatocyte swelling blocks outflow of bile from canaliculi (conjugated bilirubin)
What are the features of post-hepatic jaundice?
Due to obstruction of normal bile flow
Conjugated bilirubin accumulates in liver and is reabsorbed into the blood
What are the causes of Post-hepatic jaundice?
see hepatic jaundice
obstruction of ducts [e.g. liver fluke…]
fibrous tissue in cirrhosis
cholangitis
gall stones
pressure on ducts [abscesses, granulomas, neoplasms]
closure of excretory duct [duodenal papilla]
What can sometimes be seen histologically with jaundice?
Accumulation of bile within canaliculi and bile ducts

What are the hepatic functions?
Metabolism: Processes carbs, fats, and proteins
Detoxification: Breaks down drugs and toxins (from int tract and other organs)
Bile production: Aids fat digestion
Storage: Stores glycogen, vitamins, and iron
Synthesis: Makes proteins like albumin and clotting factors
Immune function: Filters blood and supports immune response


What does hepatic failure lead to?
Jaundice
hypoalbuminaemia (reduced synthesis & secretion of albumin → ascities)
Coagulopathy (reduced synthesis & secretion of clotting factors)
Hyperammonaemia (reduced detoxification by conversion to urea & glutamine)
(albumin helps maintain osmotic pressure of circulation)
Poral hypertension (→ ascites)
What does hyperammonaemia lead to?
Hepatic encephalopathy
Cerebral oedema (Status spongiosus)
Neuronal necrosis and swelling
Degeneration of astrocytes
What is being shown here?

Alzheimer type II astrocytes (black arrows)
Status spongiosus (cerebral oedema; arrowhead)
What is being shown here?
Liver —> portal triads lacking veins
What is being shown here?

Nodular hyperplasia
not a neoplasm
common in old dogs
single or multiple
compression of adjacent tissue (which looks normal)
contain portal areas
Describe regenerative nodules
Not neoplasm
Multiple / numerous
Adjacent tissue usually fibrotic
Loss of lobular architecture
What is being shown here?

Hepatocellular adenoma
usually single
sharply delineated
no portal areas / lobular structure
compression of adjacent tissue
may become quite large
do not metastasise (benign)

What is being shown here?



Hepatocellular carcinoma
compression & invasion of adjacent tissue, invasion of portal vessels
poorly demarcated
metastasis
What can cause Hepatocellular carcinoma?
Aflatoxins
Some viruses (hepatitis B in humans)
What is being shown here?

Bile duct adenoma (confined to one area)
often cystic [cystadenoma]
usually single
sharply delineated —> surgical management poss
compression of adjacent tissue
may become quite large
What is being shown here?


Bile duct carcinoma
commonly spreads along biliary tract
metastasis [spread to hepatic serosa, via lymph nodes to lungs]
often inducing desmoplasia (fibrosis in response to tumour → firm, nodular feel)
What is a Haemangiosarcoma?
Malignant neoplasm arising from endothelial cells
Liver can be primary site or site of metastases

Why is the liver a frequent site of metastases?
portal vein [from pancreas and intestine]
veins / arteries at sites of entry [any other neoplasms]
contact metastases [serosa; from malignant tumours in abdominal cavity; less common]
What are the different presentations of metastasis in the liver?
